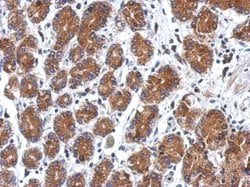

Promotional price valid on web orders only. Your contract pricing may differ. Interested in signing up for a dedicated account number?
Learn More
Learn More
Invitrogen™ SEL1L3 Polyclonal Antibody


Rabbit Polyclonal Antibody
Supplier: Invitrogen™ PA531795
Description
Recommended positive controls: NT2D1, PC-3, U87-MG, SK-N-SH. Predicted reactivity: Mouse (83%), Bovine (92%). Store product as a concentrated solution. Centrifuge briefly prior to opening the vial.
SEL1L3 is a protein coding gene.
Specifications
| SEL1L3 | |
| Polyclonal | |
| Unconjugated | |
| SEL1L3 | |
| KIAA0746; Protein sel-1 homolog 3; sel-1 suppressor of lin-12-like 3; SEL1L family member 3; SEL1L3; Sel-1L3; Suppressor of lin-12-like protein 3 | |
| Rabbit | |
| Antigen affinity chromatography | |
| RUO | |
| 23231 | |
| Store at 4°C short term. For long term storage, store at -20°C, avoiding freeze/thaw cycles. | |
| Liquid |
| Immunohistochemistry (Paraffin), Western Blot | |
| 0.92 mg/mL | |
| 0.1M tris glycine with 20% glycerol and 0.01% thimerosal; pH 7 | |
| Q68CR1 | |
| SEL1L3 | |
| Recombinant protein encompassing a sequence within the N-terminus region of human SEL1L3. The exact sequence is proprietary. | |
| 100 μL | |
| Primary | |
| Human | |
| Antibody | |
| IgG |
Product Content Correction
Your input is important to us. Please complete this form to provide feedback related to the content on this product.
Product Title
Spot an opportunity for improvement?Share a Content Correction